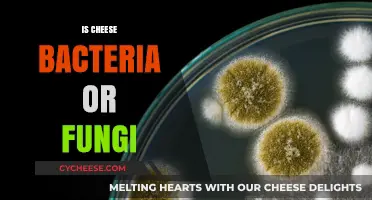
Cheese: A Delicious Product of Bacteria or Fungi Explained

Cheese is a popular and nutritious food for many, but when it comes to babies, parents often wonder if it can be binding or cause constipation. While cheese is a good source of calcium and protein, its high fat and low fiber content can sometimes slow down digestion in infants, potentially leading to firmer stools. However, the impact varies depending on the type of cheese, the amount consumed, and the baby’s individual digestive system. Mild, low-fat cheeses like mozzarella or cottage cheese are generally easier for babies to digest, whereas harder, aged cheeses may be more likely to cause constipation. It’s essential to introduce cheese in small quantities and monitor your baby’s reaction, ensuring it’s part of a balanced diet that includes plenty of fluids and fiber-rich foods to support healthy digestion. Always consult with a pediatrician before adding new foods to your baby’s diet, especially if there are concerns about constipation or allergies.
Explore related products
$21.39 $25.97
What You'll Learn
- Cheese Types for Babies: Soft, mild cheeses like cheddar or mozzarella are safest for babies
- Age-Appropriate Introduction: Introduce cheese after 8 months, when solids are well-tolerated
- Potential Allergies: Monitor for dairy allergies; consult a pediatrician if symptoms appear
- Choking Hazards: Grate or shred cheese to reduce choking risks for infants
- Nutritional Benefits: Cheese provides calcium and protein, supporting baby’s growth and development

Cheese Types for Babies: Soft, mild cheeses like cheddar or mozzarella are safest for babies
Cheese can be a nutritious addition to a baby's diet, but not all types are created equal. When introducing cheese to infants, the texture and flavor profile matter significantly. Soft, mild cheeses like cheddar or mozzarella are ideal starting points due to their ease of digestion and lower risk of allergic reactions. These varieties are less likely to cause constipation or gastrointestinal discomfort, making them safer options for babies aged 8 months and older. Always opt for pasteurized versions to eliminate the risk of harmful bacteria.
From a nutritional standpoint, cheddar and mozzarella offer calcium, protein, and vitamin B12, which are essential for bone development and overall growth. However, portion control is crucial. Start with small amounts—about 1 to 2 tablespoons—to monitor your baby’s tolerance. Gradually increase the serving size as they become accustomed to the texture and taste. Pairing cheese with soft, mashed foods like avocado or sweet potato can make it easier for babies to consume and digest.
One common concern with cheese is its potential to be binding, leading to constipation. While harder cheeses like Parmesan or aged cheddar can have this effect, softer varieties like fresh mozzarella or young cheddar are less likely to cause issues. The key lies in their moisture content; higher moisture cheeses are gentler on a baby’s digestive system. If constipation occurs, reduce the portion size or alternate with other non-binding foods like prunes or pears.
When selecting cheese for your baby, read labels carefully to avoid added preservatives or high sodium content. Organic, low-sodium options are preferable. Additionally, always supervise your baby while they eat cheese, especially if it’s cubed or shredded, to prevent choking hazards. Grating or melting cheese can further reduce risks while making it more palatable for younger infants.
Incorporating soft, mild cheeses into a baby’s diet can be a practical way to diversify their nutrient intake. By choosing the right types, monitoring portions, and pairing with complementary foods, parents can safely introduce cheese without worrying about binding or other adverse effects. Remember, every baby is different, so observe their reactions and consult a pediatrician if you have concerns.
Creative Cheese Effect: Enhance Your Photos with Fun, Gooey Magic
You may want to see also

Age-Appropriate Introduction: Introduce cheese after 8 months, when solids are well-tolerated
Introducing cheese to a baby’s diet should align with their developmental readiness, typically around 8 months of age. By this stage, most infants have begun to tolerate solid foods, and their digestive systems are better equipped to handle new textures and flavors. Cheese, a nutrient-dense food rich in calcium, protein, and fat, can be a valuable addition to their diet, but timing is crucial. Before 8 months, babies may still be adjusting to simpler solids like pureed vegetables and fruits, and their digestive enzymes might not fully process dairy proteins, potentially leading to discomfort or constipation.
When starting cheese at 8 months, begin with small, manageable portions—think a cube the size of your thumbnail or a thin, melted layer on toast. Opt for mild, low-sodium varieties like cheddar or mozzarella, as strong flavors or excessive salt can overwhelm their palate. Grating or melting cheese can also make it easier for babies to chew and swallow, reducing the risk of choking. Pairing cheese with familiar foods, such as avocado or cooked vegetables, can help them accept this new taste more readily.
While cheese can be a binding food due to its high fat and protein content, this effect is generally mild when introduced in age-appropriate amounts. However, monitor your baby’s bowel movements after introducing cheese, as some infants may experience temporary constipation. If this occurs, balance their diet with fiber-rich foods like prunes, pears, or whole-grain cereals to promote regularity. Always consult a pediatrician if you notice persistent digestive issues or signs of an allergic reaction, such as rash, vomiting, or diarrhea.
The key to successful cheese introduction lies in gradual exposure and observation. Start with once or twice a week, gradually increasing frequency as your baby adapts. By 10–12 months, most infants can handle small daily portions, provided they show no adverse reactions. Remember, cheese should complement, not dominate, their diet—prioritize a variety of foods to ensure they receive a broad spectrum of nutrients. With patience and attention to their cues, cheese can become a healthy, enjoyable part of their early eating experiences.
Creative Ways to Use Leftover Whey from Ricotta Cheese Making
You may want to see also

Potential Allergies: Monitor for dairy allergies; consult a pediatrician if symptoms appear
Introducing cheese into a baby's diet can be a delicate process, especially when considering the potential for dairy allergies. As a parent, it's essential to be vigilant and monitor your child for any adverse reactions. Dairy allergies are among the most common food allergies in infants, with symptoms typically appearing within minutes to hours after consumption. These symptoms can range from mild, such as hives or itching, to severe, like difficulty breathing or anaphylaxis.
From an analytical perspective, the risk of dairy allergies is higher in babies with a family history of allergies or those who have shown sensitivity to other foods. If your baby falls into this category, it's crucial to introduce cheese and other dairy products gradually, starting with a small amount (around 1-2 teaspoons) and monitoring for any reactions. Keep a food diary to track what your baby eats and any symptoms that arise, which can help identify potential allergens and provide valuable information for your pediatrician.
Instructively, here’s a step-by-step approach to introducing cheese while minimizing allergy risks: begin with a single type of cheese, preferably a mild variety like cheddar or mozzarella, and serve it in a small, age-appropriate portion (for babies 6-8 months old, think grated or melted cheese mixed with other foods). Wait 3-5 days before introducing another new food to isolate any allergic reactions. Common symptoms to watch for include skin rashes, vomiting, diarrhea, or respiratory issues. If any of these occur, discontinue cheese and consult your pediatrician promptly.
Persuasively, early detection of dairy allergies can prevent more severe health complications. For instance, untreated allergies can lead to chronic conditions like eczema or gastrointestinal distress. By staying proactive and observant, you can ensure your baby’s dietary journey is both safe and nutritious. Remember, while cheese can be a valuable source of calcium and protein, it’s not the only option; alternatives like fortified plant-based cheeses or other calcium-rich foods can be explored if dairy proves problematic.
Comparatively, dairy allergies differ from lactose intolerance, which involves difficulty digesting lactose rather than an immune response. Allergic reactions are typically immediate and more severe, whereas intolerance symptoms like bloating or gas may take longer to appear. This distinction is crucial when discussing cheese, as some babies may tolerate lactose-free dairy products but still react to the proteins in cheese. Always consult a pediatrician to differentiate between the two and determine the best course of action.
Descriptively, imagine your baby’s first encounter with cheese as a sensory experience—the creamy texture, the mild flavor, and the way it blends with other foods. However, this experience should be approached with caution. Start with a calm, distraction-free environment to observe your baby’s reaction closely. Note any changes in behavior, such as fussiness or discomfort, which could indicate an allergy. By combining careful observation with professional guidance, you can navigate this dietary milestone with confidence and care.
Perfect Pairings: Delicious Sides to Elevate Your Ham and Cheese Sandwich
You may want to see also
Explore related products

Choking Hazards: Grate or shred cheese to reduce choking risks for infants
Cheese, a staple in many diets, can pose a significant choking hazard for infants due to its texture and consistency. Babies, especially those under 12 months, lack the molars and chewing coordination needed to safely manage large, sticky, or hard pieces of food. Whole cubes or thick slices of cheese can easily become lodged in their throats, leading to dangerous situations. To mitigate this risk, grating or shredding cheese transforms it into a safer, more manageable form for young children.
The process of grating or shredding cheese reduces its size and alters its texture, making it easier for infants to consume without choking. Fine shreds or grated cheese can be mixed into soft foods like mashed vegetables, oatmeal, or purees, ensuring it blends seamlessly and doesn’t form large clumps. For older infants (around 9–12 months) who are practicing finger feeding, lightly grated cheese can be offered as a sprinkle on top of other foods, allowing them to pick up small, safe pieces. This method not only minimizes choking risks but also encourages self-feeding and sensory exploration.
When introducing cheese to an infant’s diet, start with mild, low-sodium varieties like cheddar or mozzarella, and always supervise mealtimes closely. Avoid hard cheeses like parmesan or string cheese, which are difficult to shred and remain a choking hazard even in smaller pieces. For babies under 6 months, cheese should not be introduced at all, as their digestive systems are not yet ready for solids. After 6 months, begin with tiny amounts of grated cheese, gradually increasing portion sizes as their chewing skills improve.
Practical tips include using a fine grater or food processor to achieve a consistent, small particle size. Store-bought shredded cheese can be used, but check for added preservatives or high sodium content, which are unsuitable for infants. Always serve cheese at room temperature to avoid hardness, and never leave a baby unattended while eating. By taking these precautions and preparing cheese appropriately, parents can safely include this nutritious food in their child’s diet without compromising safety.
Mastering Godskin Duo: Cheesy Strategies for Easy Victory in Elden Ring
You may want to see also

Nutritional Benefits: Cheese provides calcium and protein, supporting baby’s growth and development
Cheese, a dairy staple, offers a concentrated source of essential nutrients vital for a baby's growth and development. Among these, calcium and protein stand out as key contributors to building strong bones, muscles, and overall health. Calcium, a mineral critical for bone and teeth formation, is particularly abundant in cheese, making it a valuable addition to a baby's diet. For instance, just one ounce of cheddar cheese provides approximately 200 mg of calcium, which is a significant portion of the 260 mg daily calcium requirement for infants aged 7 to 12 months.
As babies transition from a milk-only diet to solid foods, incorporating cheese can be a strategic move to ensure they meet their nutritional needs. Protein, another critical nutrient found in cheese, plays a pivotal role in tissue repair, enzyme production, and immune function. A single ounce of Swiss cheese, for example, contains around 8 grams of protein, contributing to the 11 grams of protein required daily for infants aged 7 to 12 months. It's essential to choose age-appropriate cheese varieties, such as mild cheddar or mozzarella, and to introduce them in small, manageable portions to minimize the risk of choking.
When introducing cheese to a baby's diet, it's crucial to consider the recommended serving sizes and frequencies. For infants aged 6 to 9 months, start with tiny pinches of grated cheese, gradually increasing to small cubes or shreds as they approach 9 to 12 months. Aim to offer cheese 2-3 times per week, alternating with other calcium-rich foods like yogurt or fortified cereals. Be mindful of potential allergens and always consult a pediatrician before introducing new foods, especially if there's a family history of dairy allergies or lactose intolerance.
The nutritional benefits of cheese extend beyond calcium and protein, as it also contains essential vitamins like vitamin A, B12, and riboflavin, which support vision, nerve function, and energy production. However, it's essential to balance cheese consumption with other nutrient-dense foods to ensure a well-rounded diet. For example, pair cheese with fiber-rich fruits or vegetables to promote healthy digestion and prevent constipation, a common concern when introducing dairy products. By incorporating cheese strategically and in moderation, parents can harness its nutritional advantages while minimizing potential drawbacks.
In practice, integrating cheese into a baby's diet can be both simple and creative. Try melting a small amount of cheese over steamed vegetables or mixing grated cheese into whole-grain pasta for a nutritious and appealing meal. For snack time, offer small cubes of cheese alongside sliced fruits or whole-grain crackers. Remember, the goal is not to rely solely on cheese for nutrition but to use it as a complementary food that enhances the overall dietary profile. By doing so, parents can support their baby's growth and development while fostering a positive and varied eating experience.
Mastering the Art of Bandaging Cheese: A Step-by-Step Guide
You may want to see also
Frequently asked questions
Cheese is not typically binding for babies; in fact, it can sometimes have the opposite effect due to its lactose content, which may cause loose stools in some infants.
Cheese is generally not a common cause of constipation in babies. However, if consumed in large amounts, it might contribute to firmer stools in some cases due to its low fiber and high fat content.
Babies can start eating cheese once they begin solids, usually around 6 months of age. Start with small amounts of mild, pasteurized cheese to monitor for any reactions.
Cheese can affect a baby's digestive system, especially if they are lactose intolerant or sensitive to dairy. It’s important to introduce it gradually and watch for signs of discomfort.
Mild, pasteurized cheeses like cheddar, mozzarella, or Swiss are good options for babies. Avoid soft, unpasteurized cheeses like Brie or blue cheese due to the risk of bacteria.